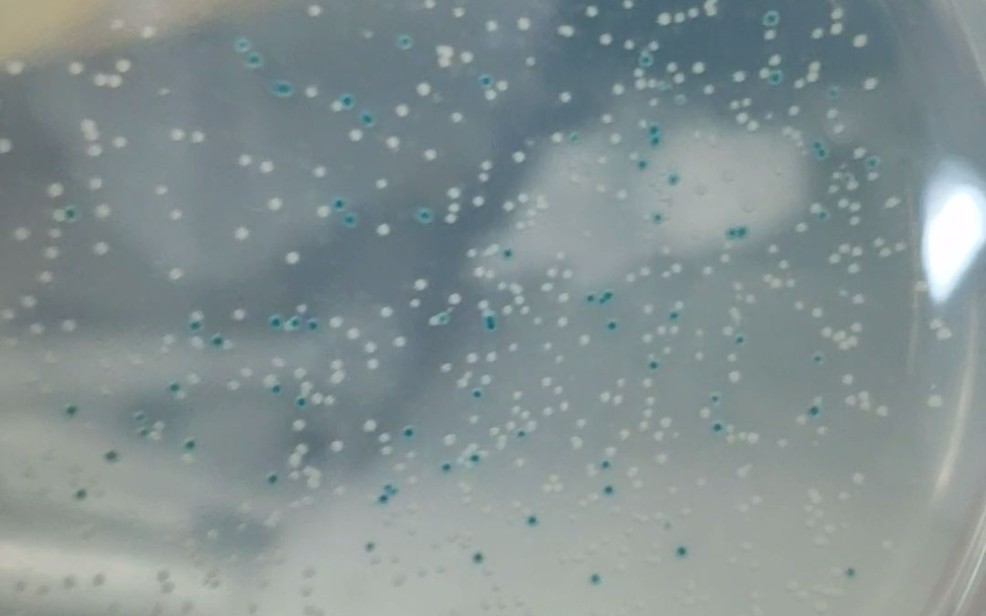
【实验】1分钟学会x-gal怎么配,蓝白斑筛选怎么做,iptg怎么配_哔哩

蓝白斑筛选

蓝白斑筛选一种很炫的东西
图片尺寸560x560
图二 蓝白斑筛选中不同片段大小的整合
图片尺寸1076x423
蓝白斑筛选法
图片尺寸507x341
【求助】载体构建 及蓝白斑筛选实验 急需帮助!
图片尺寸1545x1523
记一次失败的蓝白斑筛选
图片尺寸480x640
a 全自动菌落计数分析仪 蓝白斑筛选是根据载体的遗传特征筛选重组子
图片尺寸400x232
基因工程-重组体克隆的筛选和鉴定ppt
图片尺寸1080x810
蓝白筛选的介绍
图片尺寸243x264
哈哈第一次做蓝白斑
图片尺寸1080x810
默克sigma实验分享|蓝白斑筛选和菌落筛选实验方案
图片尺寸810x389
设计适用于蓝白斑筛选的基因工程菌为β-半乳糖苷酶缺陷型
图片尺寸536x472
【实验】1分钟学会x-gal怎么配,蓝白斑筛选怎么做,iptg怎么配_哔哩
图片尺寸986x616
蓝白斑筛选的原理
图片尺寸2304x1440
蓝白斑筛选的蓝白斑筛选原理
图片尺寸500x301
蓝白斑筛选的原理是什么?
图片尺寸720x1029
老师想蓝白斑筛选结果全部二十多个培养基只有一个长出来菌落了连老师
图片尺寸1080x1440
北京华越洋生物
图片尺寸980x880
分子生物学 蓝白斑筛选原理
图片尺寸863x540
细菌双杂交系统的改进
图片尺寸557x513
感受态制备,蓝白斑筛选ppt
图片尺寸1200x8915